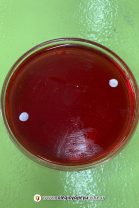

Los alumnos de 6to año en orientación Ciencias Naturales, en el espacio curricular Salud, luego de abordar el tema Bacterias, entre las noxas que nos ocasionan enfermedades, realizaron el cultivo de diferentes microorganismos. En una semana, realizaran la caracterización de las colonias y la observación microscópica.
Noticia anterior/siguiente:

Seguí al colegio